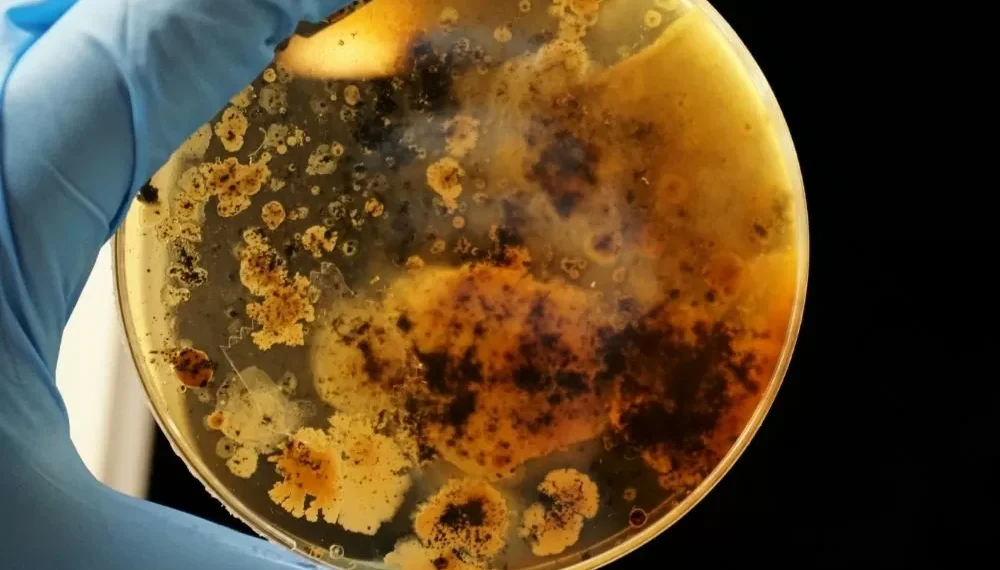
Uma em cada seis infecções bacterianas no mundo é resistente a antibióticos, alerta OMS

Dados são do mais recente relatório do Sistema Global de Vigilância da Resistência e do Uso de Antimicrobianos (Glass), que analisou informações de 104 países entre 2018 e 2023. Este relatório é uma importante ferramenta para entendermos a situação atual da resistência antimicrobiana e como ela pode afetar a saúde pública em todo o mundo.
A resistência antimicrobiana é um fenômeno que ocorre quando bactérias, vírus, fungos e outros microrganismos se tornam resistentes aos medicamentos que antes eram eficazes no seu combate. Isso acontece devido ao uso excessivo e inadequado de antibióticos e outros antimicrobianos, tanto em humanos quanto em animais. Com o passar do tempo, esses microrganismos se adaptam e se tornam mais fortes, tornando os tratamentos cada vez menos eficazes.
O relatório do Glass traz dados alarmantes sobre a resistência antimicrobiana. Segundo o documento, a resistência a antibióticos comumente usados para tratar infecções bacterianas, como a pneumonia e a gonorreia, está aumentando em todo o mundo. Além disso, a resistência a medicamentos usados para tratar infecções hospitalares, como a bactéria Staphylococcus aureus resistente à meticilina (MRSA), também está em ascensão.
Esses dados são preocupantes, pois a resistência antimicrobiana pode levar a um aumento no número de mortes por infecções que antes eram facilmente tratáveis. Além disso, o tratamento de infecções resistentes a medicamentos é mais caro e pode levar a um aumento nos custos de saúde.
No entanto, o relatório também traz boas notícias. Ele mostra que alguns países estão tomando medidas eficazes para combater a resistência antimicrobiana. Por exemplo, a Dinamarca conseguiu reduzir o uso de antibióticos em animais de produção em 14% entre 2010 e 2018. Além disso, a Tailândia implementou um programa de vigilância para detectar e controlar a resistência antimicrobiana em hospitais, o que resultou em uma redução de 50% nos casos de infecções hospitalares resistentes a medicamentos.
Esses exemplos mostram que é possível combater a resistência antimicrobiana por meio de ações efetivas. E é exatamente isso que o relatório do Glass nos mostra: a importância de implementar medidas de prevenção e controle da resistência antimicrobiana em todo o mundo.
Uma das principais recomendações do relatório é a implementação de programas de vigilância da resistência antimicrobiana em todos os países. Isso permitirá que os governos monitorem a situação e tomem medidas preventivas antes que a resistência se torne um problema de saúde pública. Além disso, é necessário promover o uso racional de antibióticos e outros antimicrobianos, tanto em humanos quanto em animais, para evitar o desenvolvimento de resistência.
Outra medida importante é investir em pesquisa e desenvolvimento de novos medicamentos e tratamentos para combater infecções resistentes a medicamentos. Atualmente, existem poucos novos antibióticos sendo desenvolvidos, o que torna ainda mais urgente a necessidade de investimentos nessa área.
É importante ressaltar que a resistência antimicrobiana é um problema global e que requer ação conjunta de todos os países. O relatório do Glass é um passo importante para entendermos a situação atual e traçarmos estratégias eficazes para combater esse problema.
Portanto, é fundamental que os governos, profissionais de saúde e a população em geral estejam cientes da gravidade da resistência antimicrobiana e tomem medidas para preveni-la. A